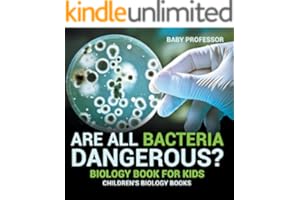
kindle best category lists

Global score of the book idea "biology book"
Competition
A
Great idea. Few best sellers explicitly cover this theme.
Profitability
D
Average sales volume are mostly under the $1000/month mark, even for top selling books. If the difficulty is too high, it may not be worth the effort. Releasing multiple books is highly recommended.
Difficulty
A
You can easily make it to most best seller lists with less than 3 sales a day on average. This topic is ideal for new writers. Provided that the profitability and competition scores check out, you found your gem!
Niche
B
Good compromise between a niche subject and an active reader audience
Your passion
C
After all, you've got to have passion and dedication about this idea to make it work.
Technical information related to books about "biology book"
Average book price
$14.09
Average stars per book
Average reviews per book
6
Average book length
213 pages
Average title length
11 words
Top 5 best selling authors
Barron's Educational Series , Chris Ferrie , Venki Ramakrishnan , Robert D. Griffin , Kaplan Test Prep
Top 5 best selling publishers
Self Published , Collins Reference; First Edition , Kaplan Test Prep , W. W. Norton & Company; Third edition , Paradox Press
Best sellers related to "biology book"
Sample of categories featuring these books
Click here for more categories directly connected to "biology book"
| Category name | Best seller rank | 50th book's rank | Median sales($) | Median price ($) | Volatility (%) | New releases (%) | Self pub.(%) | KDP Select (%) | Competition |
|---|
Related ideas and keywords

Why We Die: The New Science of Aging and the Quest for Immortality
Venki Ramakrishnan
The Biology Coloring Book
Robert D. Griffin
MCAT Biology Review 2025-2026: Online + Book (Kaplan Test Prep)
Kaplan Test Prep
The Biology of Cancer
Robert A. Weinberg
Binary: Debunking the Sex Spectrum Myth
Zachary A Elliott
CLEP® Biology Book + Online (CLEP Test Preparation)
Laurie Ann Callihan Ph.D.
Fibers: Geoengineering Morgellons DNA Assault Without Your Approval
IAN TRAFFORD WALKER
Exploring Botany: From Cells to Ecosystems
Vikash Dabriwal
Where Biology Ends and Bias Begins: Lessons on Belonging from Our DNA
Shoumita Dasgupta
Herbicides and Plant Physiology
Andrew H. Cobb
Design Elements of Complex Systems
Avi Ma'ayan
Human Embryology and Developmental Biology E-Book
Bruce M. Carlson
You are limited to 3 queries per day.
Try unlimited access for $7.99